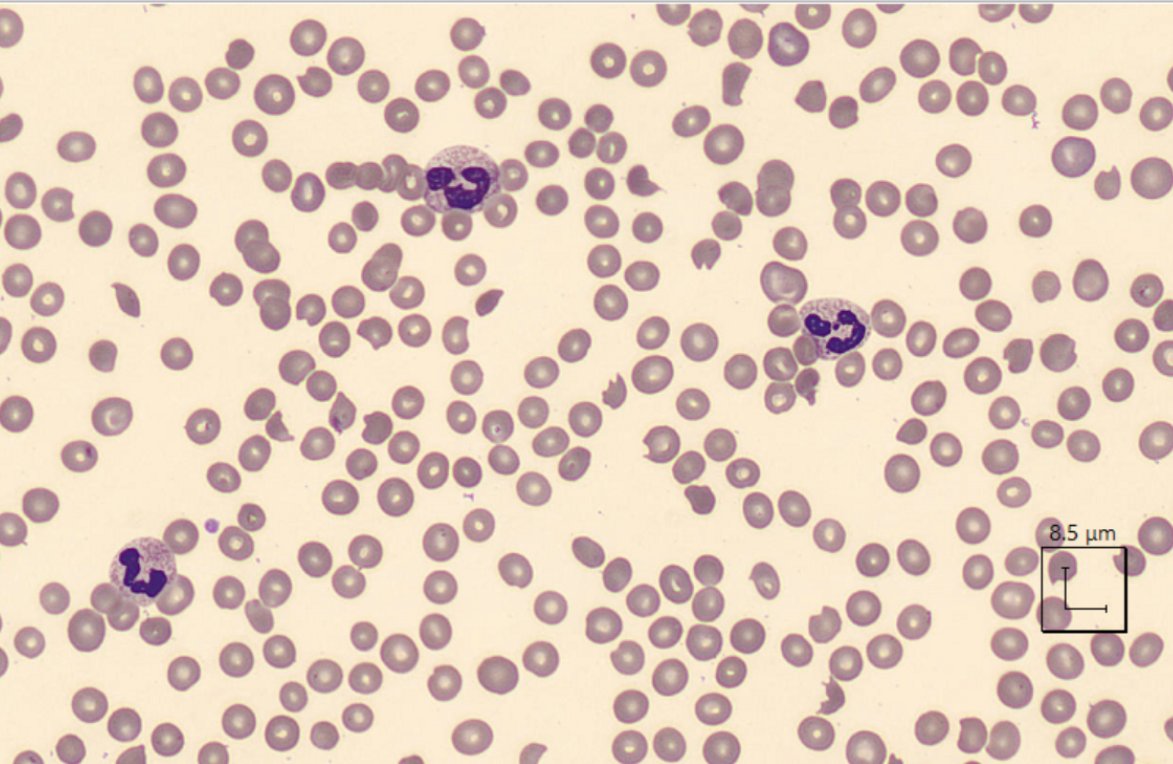

There are several different TMAs. Usually we give three categories:
TTP, Shiga-toxic STEC-HUS, ‘atypical’ HUS
But don’t forget there are several others including DIC and HELLP
TTP, Shiga-toxic STEC-HUS, ‘atypical’ HUS
But don’t forget there are several others including DIC and HELLP
100% of TTP patients have microthrombi on biopsy. Late in disease, severe renal failure occurs. It just doesn't have a predilection for the kidney
Lets compare to other TMAs:
TTP acute renal failure 5%
HELLP acute renal failure 8%
DIC kidney injury 25-40% (but multifactorial)
Lets compare to other TMAs:
TTP acute renal failure 5%
HELLP acute renal failure 8%
DIC kidney injury 25-40% (but multifactorial)
The hemolytic “uremic” syndromes (HUS) always cause kidney failure. So there must be something specifically nephrotoxic about them.
We should stop and review TMA physiology a bit more to find the differences...
We should stop and review TMA physiology a bit more to find the differences...
Our patient was empirically treated with plasma exchange, thus removing the inhibitor while giving fresh ADAMTS13 in donor plasma. They responded with normalization of counts and a few days later the lab confirmed her original bloodwork had an undetectable ADAMTS13 level.
Not to go into too much detail, but the alternative pathway relies on Factor B/C3bBbP, and HUS occurs when we can’t regulate/inhibit this pathway. Regulation depends onsoluble factors (factor H), or membrane bound factors (CD55 and CD59 for example).
We only have theories for why the kidney is vulnerable:
- glomerular capillary has less membrane-bound complement regulators (eg CD55 and CD59)
- the glycocalyx (cell membrane microenvironment) may recruit less inhibitors like factor H
- capillary fenestration inc surface area
- glomerular capillary has less membrane-bound complement regulators (eg CD55 and CD59)
- the glycocalyx (cell membrane microenvironment) may recruit less inhibitors like factor H
- capillary fenestration inc surface area
Loading suggestions...